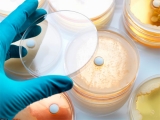
Recomendaciones de expertos para evitar la resistencia a los antibi�ticos

Buenos Aires, Sábado 04 de Abril de 2026
Acerca de EsteticaMedica | Clasificados | Eventos | Actividades | Staff | Publicidad | Contacto
.doc
08.08.2014 | Mercado paralelo de productos
Tratamientos estéticos de bajo costo: más baratos pero más peligrosos
Era inevitable: la medicina estética, con sus insumos importados en dólares, también cedió a la tentación de abaratar los costos con "un mercado paralelo" de productos, como ya lo denominan los especialistas que resisten esa tendencia peligrosa para la salud.
04.07.2014 | Documento de la SEME y Pfizer
Editan una guía de ayuda a los médicos estéticos para el tratamiento del tabaquismo
La cuestión estética es una de las principales causas para dejar de fumar: motiva a 6 de cada 10 fumadores. Las consultas más frecuentes relacionadas con el tabaquismo son la fragilidad capilar, el envejecimiento prematuro y los dientes amarillentos.
10.06.2014 | Dispositivos médicos portátiles
Cuerpos conectados a internet: la salud online y compartida en Facebook
La tecnología portátil y el registro online de la actividad diaria sentó las bases para los dispositivos médicos inalámbricos que monitorean las funciones corporales y envían los datos a un sitio web. Pero también para compartirlos en redes sociales.
09.06.2014 | ETICA VS NEGOCIO
Los cupones de descuento en estética: outlet o excelencia?
La estética no se puede vender ni consumir como cualquier mercadería de góndola, en la que dos amigas con un 2×1 reciben el mismo tratamiento, durante el mismo tiempo, con el mismo producto o aparato, por un precio menor al que maneja el resto del mercado. Cada paciente requiere un tiempo y un tratamiento especial, pensado específicamente para su problemática.
01.05.2014 | Organización Mundial de la Salud (OMS)
Recomendaciones de expertos para evitar la resistencia a los antibióticos
La OMS advirtió recientemente que "muchas infecciones comunes dejarán de tener cura y podrían volver a matar". Ahora, una comisión de expertos mundiales alertó que la existencia de cepas de bacterias resistentes a los antibióticos representa unas de las amenazas más graves de la medicina moderna. Los especialistas hacen un llamado sin precedentes para que haya una coordinación global que contrarreste esta amenaza.
10.04.2014 | El caso de Angelina Jolie
Cirugías preventivas: un debate práctico, ético y filosófico
La medicina moderna puede prever cada vez con más precisión de qué nos podríamos morir. Pero, ¿se puede cambiar el curso de un individuo predestinado por su composición genética a través de cirugías preventivas radicales? ¿Y hacia dónde nos conducirían esas cirugías? El caso de Angelina Jolie.
27.03.2014 | TENDENCIAS
Medicamentos y medicina personalizada
En la actualidad, está la tendencia de realizar mayores esfuerzos en estudiar y hacer recomendaciones a la persona, en lugar, de enfoques generalizados. Se toma al individuo como persona. Los medicamentos que se diseñan están orientados a actuar en un objetivo (receptor) preciso, y evitar que actúen al mismo tiempo en otros receptores, motivo por el cual se produce la toxicidad.
13.03.2014 |
Médicos cuestionan el proyecto de prohibición de las cirugías a menores de edad
La propuesta legislativa fue presentada por la diputada Mara Brawer y se basó en el incremento del número de consultas por intervenciones plásticas. La primera objeción para que la iniciativa prospere es el reconocimiento por parte de los propios especialistas de que en la Argentina hoy hay cifras claras y sistematizas sobre el fenómenos de los "under 18" y las cirugías estéticas.
10.03.2014 | PROPUESTA DE UNA DIPUTADA
Proyecto para prohibir las cirugías estéticas a menores de 18 años
Es un proyecto de ley que, por su solo título, promete causar un intenso debate. "Prohibir la realización de cirugías estéticas en personas menores de 18 años" es la propuesta de la diputada kirchnerista Mara Brawer para "preservar la salud física y psíquica" de los jóvenes ante la imposición de "patrones culturales sobre cómo debería ser el cuerpo ideal".
05.03.2014 | INTERNET
La Wikipedia se convirtió en la principal fuente de consulta de médicos y pacientes
Una empresa especializada en el manejo de datos y estadísticas del mundo medicinal presentó un estudio donde muestra que la Wikipedia se convirtió en la principal fuente de consulta de los médicos y pacientes. El 50% de los entrevistados aseguró que bucea por la enciclopedia virtual para indagar sobre cuestiones médicas, en especial con respecto a síntomas de enfermedades.
20.02.2014 | NUEVOS DISPOSITIVOS PORTATILES
Adiós al estetoscopio?
Según la publicación Global Heart, el estetoscopio agoniza: está en peligro de ser confinado a un museo de historia tras ser sustituido por dispositivos con tecnología de punta. Ha estado en el mundo de la medicina durante casi 200 años. Tiempo en el cual es muy poco lo que ha cambiado, más allá de modificar el modelo original de un solo auricular a dos en 1860.
07.01.2014 | AUSTRALIA
Arte y estética: clases de dibujo y de escultura para cirujanos plásticos
Llamado "El Arte de la Reconstrucción", el curso consiste en clases de dibujo y de escultura con arcilla. Los alumnos son todos cirujanos plásticos y estudiantes de medicina. Y el objetivo es darles a ambos un mejor sentido de la forma. El énfasis está en las aplicaciones quirúrgicas, y el foco es la cabeza, el cuello y la reconstrucción del seno.
03.01.2014 |
Comics que ayudan a mejorar la relación médico-paciente
Una investigación reciente determinó que las habilidades de comunicación del doctor no sólo aumentan la satisfacción del enfermo, sino también puede ayudar a mejorar su salud física, aliviando síntomas de dolor y mejorando los niveles de presión arterial y de glucosa en la sangre.
25.10.2013 | TEMAS LEGALES
Un fallo de la Justicia española y el valor subjetivo de la satisfacción estética
La Audiencia Provincial de Madrid ha resuelto en apelación el recurso interpuesto contra la resolución dictada por el Juzgado de 1ª Instancia que condenó a un cirujano plástico y a una institución clínica a indemnizar a la paciente en 62.500 euros por no haber obtenido el resultado deseado en una mastopexia con mamoplastia de aumento, revocando la Audiencia Provincial la Sentencia y desestimando íntegramente la demanda formulada contra el facultativo y el centro médico.
10.09.2013 | TRATAMIENTOS FACIALES
La Estética que imita los rasgos: el concepto de belleza facial
Los labios de Angelina Jolie, la nariz de Jennifer Connelly o los pómulos e Jennifer López. Deseamos modelos de belleza ajenos y los queremos aplicar sin ningún tipo de evaluación a nuestro rostro. Cómo mejorar tu rostro sin que parezca una imitación de molde. Cinco tratamientos faciales que mantienen los rasgos propios y los mejoran, porque son mínimamente invasivos.
EL QUE BUSCA, ENCUENTRA.
Estetica-medica.info ofrece a todos los profesionales, empresas e instituciones del rubro la oportunidad de publicar gratuitamente en sus Clasificados, que cuenta con 3 tipos de avisos: Trabajo Pedido (búsqueda de personal), Trabajo Ofrecido (profesionales que buscan trabajo) y oportunidades Comerciales (compra/venta particular de equipamiento usado, fondos de comercio, alquiler, permutas, etc.).
Para publicar su aviso, complete, a continuación, el formulario online.
Encuesta
Qué le parece el nuevo sitio de EstéticaMédica.info?
VIDEOVITRINA > EQUIPOS BELLCURVS
Todos los equipos de Bellcurvs Medical & Aesthetic. Venta y alquiler. Más info
------------------------------------------------------------------------------------
Antiaging
La importancia de las vitaminas en la medicina antiaging

Lo que se trata de evitar es el proceso de oxidación prematuro de las células y, por consiguiente, su mal funcionamiento por carencias de ciertas vitaminas imprescindibles para el buen funcionamiento del medio interno. Su correcta reposición conlleva una buena evaluación médica personalizada.
Revitalización biológica y celuloterapia ortomolecular

Envejecer es sinónimo de desvitalización. En cambio, la terapia biológica celular equivale a revitalizar. Es una verdadera revitalización celular. Todos los órganos de nuestro cuerpo pueden ser revitalizados con una terapia específica. El principio básico de la terapia celular es la órgano-especificidad: la piel cura a la piel, el hígado cura al hígado y así será para cada órgano o tejido tratado.
Células madre: pilar básico del proceso de renovación celular

Se multiplican mediante divisiones mitóticas para dar lugar a otras células madre idénticas. También tienen la capacidad de diferenciarse en diversos tipos de células especializadas. En tecnología cosmética hace referencia principalmente a activos de origen vegetal capaces de activar el metabolismo celular.
Neuroplasticidad, nootrópicos y regeneración neuronal

Proceso continuo que modifica las redes neuronales existentes haciendo adaptaciones estructurales y funcionales en las sinapsis, la neuroplasticidad actúa como respuesta a los cambios en el comportamiento. En otras palabras, un “recableado” del circuito neuronal cada vez que se aprende algo nuevo.
Terapia de Reemplazo Hormonal Bioidéntica, TRHB

Lo primero que hay que hacer es medir hormonas para ver en qué niveles se encuentran. Una vez que se decide qué hay que suplementar, se determina la dosis y modo de administración y se le explica al paciente; después la idea es chequear los niveles hormonales a los dos meses. El tratamiento suele extenderse por tres años en mujeres con premenopausia.
El rol del gen Sirt1 en el proceso de envejecimiento

Los telómeros se acortan de forma natural con la edad, pero las conductas poco saludables pueden hacer que se acorten antes, inactivando el gen Sirt1 y acelerando los procesos de envejecimiento. La buena noticia es que científicos demostraron que es posible volver a activarlo.